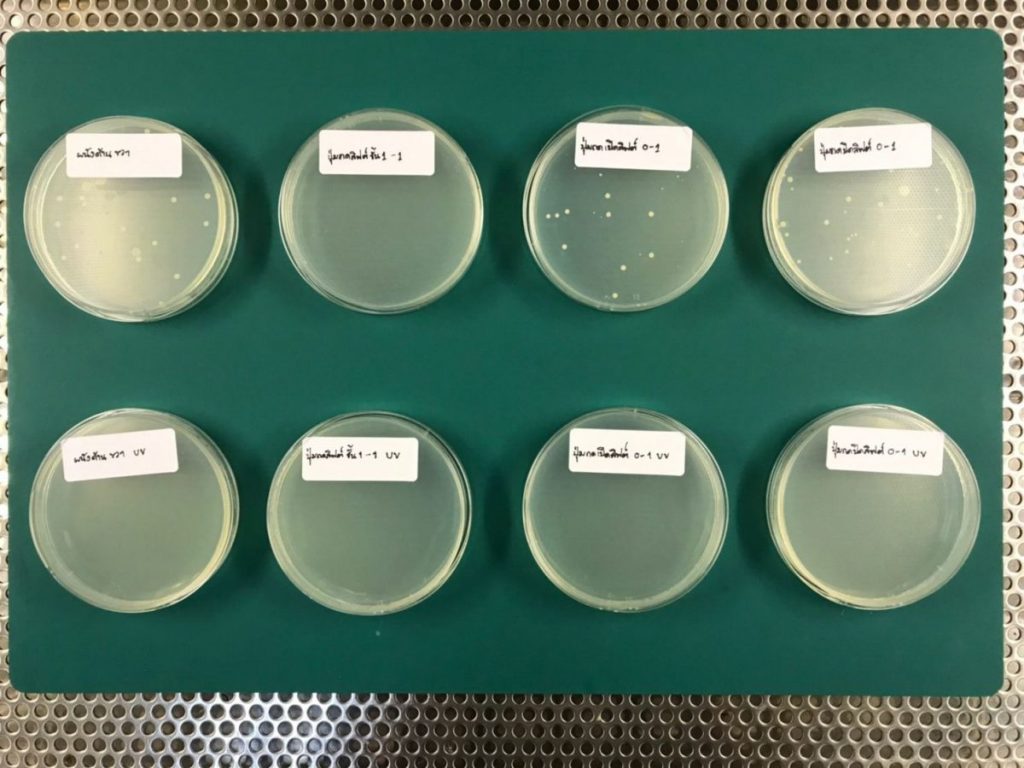

สวทช. – จุฬาฯ พัฒนาเครื่อง Germ Saber Robot ฆ่าเชื้อก่อโรคโควิด-19 ด้วยแสงยูวี ภายใน 30 นาที
ศูนย์เทคโนโลยีเพื่อความมั่นคงของประเทศและการประยุกต์เชิงพาณิชย์ (NSD) หน่วยงานภายใต้สำนักงานพัฒนาวิทยาศาสตร์และเทคโนโลยีแห่งชาติ (สวทช.) ร่วมกับสถาบันวิจัยเทคโนโลยีชีวภาพและวิศวกรรมพันธุศาสตร์ จุฬาลงกรณ์มหาวิทยาลัย พัฒนาและทดสอบ นวัตกรรมหุ่นยนต์ฆ่าเชื้อโรคด้วยแสงยูวี หรือ “Germ Saber Robot” ซึ่งเป็นหุ่นยนต์ทำหน้าที่ฆ่าเชื้อก่อโรคโควิด-19 ด้วยแสงยูวี (UV) สามารถเข้าถึงการฆ่าเชื้อโรคในพื้นที่เฉพาะและจุดเสี่ยงโรคต่างๆ ได้ดี เนื่องจากระหว่างการฆ่าเชื้อโรค พื้นที่เหล่านั้นจะต้องปลอดคน เพราะการใช้แสงยูวีแม้จะสามารถฆ่าเชื้อโรคได้ดี แต่ต้องระมัดระวังหากนำไปใช้ไม่ถูกวิธีอาจเป็นอันตรายต่อมนุษย์ได้


ดร.ศิวรักษ์ ศิวโมกษธรรม ผู้อำนวยการศูนย์เทคโนโลยีเพื่อความมั่นคงของประเทศและการประยุกต์เชิงพาณิชย์ (NSD) สวทช. เปิดเผยว่า หุ่นยนต์ฆ่าเชื้อไวรัสก่อโรคโควิด-19 ด้วยแสงยูวี หรือ “Germ Saber Robot” ที่พัฒนาขึ้นนี้ประกอบด้วยหลอดยูวี-ซี (UV-C ) ขนาดพลังงานรวม 300 วัตต์ พร้อมชุดควบคุมไฟ มีความพิเศษตรงที่สามารถบังคับให้ขับเคลื่อนไปยังจุดต่างๆ ผ่านอุปกรณ์ควบคุม “รีโมตคอนโทรล” เพื่อสั่งการให้หุ่นยนต์เดินหน้า ถอยหลัง เลี้ยวซ้าย เลี้ยวขวาและหมุนตัวแบบ 360 องศา เพื่อประสิทธิภาพในการฆ่าเชื้อโรคทุกสภาพพื้นที่
รังสีอัลตราไวโอเล็ตหรือแสง UV เป็นสเปกตรัมของคลื่นแม่เหล็กไฟฟ้าในช่วง 10 นาโนเมตรถึง 400 นาโนเมตร ซึ่งมีความถี่ที่สูงกว่าที่ตาเรามองเห็นได้ โดยหุ่นยนต์ “Germ Saber Robot” ที่พัฒนาขึ้นนี้ ใช้แสง UV-C (ความยาวคลื่นอยู่ในย่านความถี่ประมาณ 250 นาโนเมตร) เป็นแสง UV ที่มีประสิทธิภาพสูงในการกำจัดสิ่งมีชีวิตขนาดเล็กหรือเชื้อโรคต่างๆ ที่ความยาวคลื่นนี้แสง UV จะทำลายดีเอ็นเอของสิ่งมีชีวิตขนาดเล็กอย่างไวรัส แบคทีเรีย เชื้อรา และเชื้อโรคชนิดต่างๆ หยุดยั้งประสิทธิภาพในการแพร่พันธุ์และฆ่าพาหะเหล่านี้ในที่สุด
การนำหุ่นยนต์ฆ่าเชื้อโควิด-19 ด้วยแสงยูวี หรือ UV “Germ Saber Robot” มาใช้ประโยชน์ในช่วงที่ประเทศไทยมีการระบาดของโรคโควิด-19 จะช่วยให้สถานที่ต่างๆ ทั้งภาครัฐและเอกชนสามารถประหยัดค่าใช้จ่ายจากน้ำยาฆ่าเชื้อ ช่วยลดการตกค้างหรือปนเปื้อนของสารเคมีในน้ำยาฆ่าเชื้อ ที่สำคัญหุ่นยนต์ฆ่าเชื้อโรคสามารถฆ่าละอองฝอยของเชื้อที่ลอยในอากาศได้ และยังสามารถใช้ฆ่าเชื้อบนพื้นผิวของอุปกรณ์เฉพาะ เช่น อุปกรณ์อิเล็กทรอนิกส์ อุปกรณ์การแพทย์ ที่ไม่สามารถโดนน้ำหรือน้ำยาเคมีได้ เป็นต้น”
ดร.ศิวรักษ์ กล่าวต่อว่า สำหรับการพัฒนาหุ่นยนต์ “Germ Saber Robot ทีมวิจัยต้องการช่วยบรรเทาสถานการณ์การระบาดของโรคโควิด-19 ในยามที่ขาดแคลนอุปกรณ์ทางการแพทย์ ทั้งหน้ากากอนามัย แอลกอฮอล์ฆ่าเชื้อและน้ำยาฆ่าเชื้อโรคต่างๆ จึงเร่งผลิตหุ่นยนต์ฆ่าเชื้อก่อโรคโควิด-19 ขึ้นมา เพื่อเป็นอุปกรณ์เสริมในการฆ่าเชื้อไวรัสก่อโรคโควิด-19 ที่ใช้งานได้สะดวกทุกที่และตลอดเวลา โดยการฆ่าเชื้อโรคในรัศมีโดยรอบ 1-2 เมตร เป็นระยะเวลา 15-30 นาทีต่อจุด จะช่วยฆ่าเชื้อโรคบนพื้นผิวต่างๆ ได้

ทั้งนี้ทีมวิจัยเตรียมความพร้อมของหุ่นยนต์ฆ่าเชื้อก่อโรคโควิด-19 ด้วยแสงยูวี โดยวางแผนนำร่องทดสอบการใช้งานที่สถานพยาบาลแห่งแรกคือ โรงพยาบาลจุฬาลงกรณ์และหน่วยงานต่างๆ ต่อไป สำหรับหน่วยงานหรือผู้ที่สนใจให้ทีมวิจัยทำการผลิต หรือนำไปทดลองใช้งานสามารถติดต่อได้ที่ ดร.ศิวรักษ์ ศิวโมกษธรรม ผู้อำนวยการศูนย์เทคโนโลยีเพื่อความมั่นคงของประเทศและการประยุกต์เชิงพาณิชย์ สวทช. โทร. 02-564-7000 กด 2521
เรื่องอื่นๆ ที่น่าสนใจ